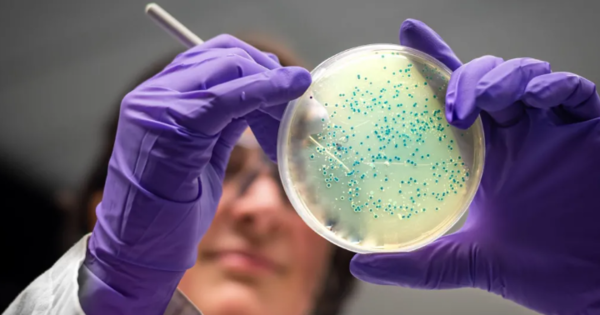
(사진=게티이미지)

[디지털비즈온 송민경 기자] 미국 매사추세츠 공과대학교(MIT) 연구진이 인공지능(AI)을 활용해 성병 원인균인 약물 내성 임질균과 치명적 감염을 일으키는 메티실린 내성 황색포도상구균(MRSA)을 겨냥한 잠재적 항생제 두 종을 새롭게 설계했다고 14일(현지시간) BBC, MIT News 등 외신이 보도했다.
연구에 따르면, AI가 원자 단위에서부터 새롭게 디자인한 이 화합물들은 실험실과 동물 실험에서 슈퍼박테리아를 억제하는 성과를 보였다. 다만 실제 처방이 가능하기까지는 추가적인 개선과 임상시험 등 수년간의 과정이 남아 있다고 MIT 연구진은 덧붙였다.
항생제는 세균을 죽이는 역할을 하지만, 오남용으로 인해 내성이 생기면서 매년 전 세계에서 백만 명 이상이 치료 불가능한 감염으로 목숨을 잃고 있다. 새로운 항생제가 수십 년간 거의 개발되지 못한 가운데, 이번 연구는 “항생제 발견의 두 번째 황금기”를 열 수 있다는 기대를 모으고 있다.
MIT 연구팀은 기존에 알려진 수천 개의 화합물을 검색하는 수준을 넘어, 생성형 AI를 활용해 아예 처음부터 새로운 항생제를 설계했다.
연구는 학술지 셀(Cell)에 '새로운 항생제 설계를 위한 생성적 딥 러닝 접근 방식'으로 게재되었다.
총 3천600만 개의 화합물을 탐색했으며, 이 과정에서 AI는 탄소, 수소, 산소, 질소 등 원자 구조와 세균 성장 억제 데이터 간의 관계를 학습했다고 밝혀졌다.
MIT 연구팀은 해당 연구에서 두 가지 접근 방식을 사용했다고 공개했으며, 첫째는 8~19개의 원자로 구성된 수백만 개의 화학 조각을 탐색해 유망한 구조를 바탕으로 항생제를 조합하는 방법이었고, 둘째는 처음부터 AI에 자유롭게 설계를 맡기는 방식이었다. 이 과정에서 기존 항생제와 지나치게 유사한 구조나 인간에게 독성을 띨 수 있는 물질은 걸러냈다고 밝혔다.

제작된 화합물은 임질균과 MRSA에 감염된 실험용 쥐에 투여돼 효과를 보였다. MIT의 제임스 콜린스 교수(Prof James Collins)는 “생성형 AI로 완전히 새로운 항생제를 설계할 수 있다는 점을 입증했다”며 “값싸고 빠르게 분자를 설계해 슈퍼박테리아와의 싸움에서 우위를 점할 수 있다”고 강조했다. 다만, 연구진은 아직 임상시험 단계에 들어가기 전이며, 향후 1~2년간 추가적인 정제 과정이 필요하다고 밝혔다.
전문가들은 이번 성과가 항생제 발견에 있어 “매우 중요한 진전”이라고 평가하면서도, 실제 환자에게 투여되기까지 안전성과 효능 검증이라는 오랜 과정이 남아 있다고 지적했다.
임페리얼 칼리지 런던(Imperial College London)의 앤드류 에드워즈 박사(Dr Andrew Edwards)는 “AI가 신약 발견과 개발을 크게 개선할 잠재력을 지니지만, 안전성과 효능 검증은 여전히 필수”라고 언급했다.
새로운 항생제가 개발되더라도 내성 발생을 막기 위해 가능한 적게 사용해야 하므로 상업적 수익을 내기 어렵다는 점이 걸림돌로 지적된다. 워릭대학의 크리스 도우슨 교수는 “이번 연구는 항생제 발견에서 중요한 전진”이라고 평가하면서도, “실질적으로 가치가 낮은 의약품을 어떻게 상업적으로 지속 가능하게 만들 것인가”라는 과제가 남아 있다고 덧붙였다.

